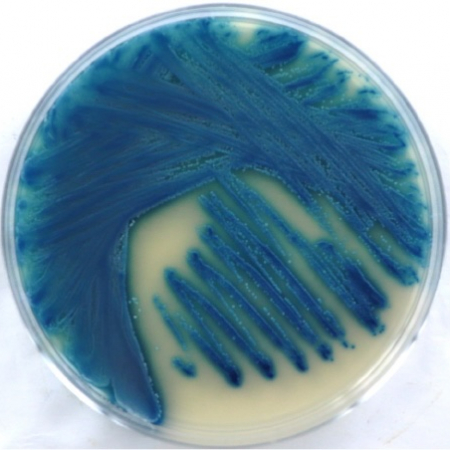
Candida blankii Candida blankii

The Mycology Laboratory serves as a comprehensive reference facility for all NYSDOH licensed clinical laboratories including: hospitals, academic medical centers, county health departments and commercial laboratories.
The laboratory houses a fungal culture collection repository, an outstanding resource for assay development, distribution and sale.
Research and development efforts complement diagnostic programs by focusing on innovations in fungal diagnostics and antifungal testing, mechanisms of fungal pathogenesis, and molecular epidemiology. These activities are carried out in collaboration with scientists at the Wadsworth Center and investigators from around the globe. Excellent opportunities are available for the training of undergraduate, graduate students, post-doctoral fellows and clinical laboratory personnel.
History
The Wadsworth Center Mycology Laboratory has a long history of excellence in both basic and applied research. The laboratory has made many notable contributions to the field with the most famous being the discoveries of the antifungal drug ‘nystatin’ by Drs. Rachel Fuller Brown and Elizabeth Lee Hazen, and the cryptococcal latex agglutination test by Dr. Morris Gordon.